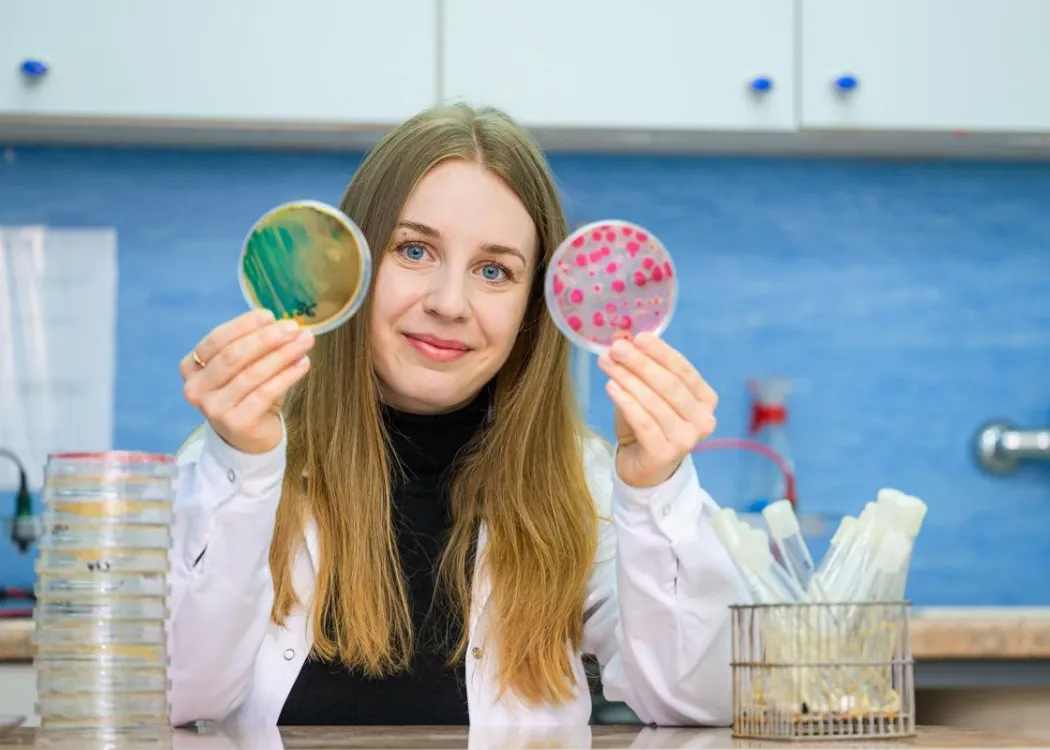
Małgorzata Czatzkowska w laboratorium

21 Maja 2025
Aktualności
Co w programie Fundacji na rzecz Nauki Polskiej jest brane pod uwagę przy ocenie dorobku?
Ocenie podlegał całokształt działalności naukowej przypisany do poszczególnych obszarów badań. Pod uwagę brano między innymi dorobek naukowy, czyli publikacje, uczestnictwo w projektach naukowych, a także oryginalność dokonań badawczych. Myślę, że duży wpływ na ocenę miało również określenie swoich planów naukowych na kolejne lata. Od kandydatów wymagano także podsumowania dotychczasowych lat działalności w nauce poprzez wyróżnienie jednego, najważniejszego dokonania.
Co było dla pani najważniejszym osiągnięciem naukowym?
Wykazałam, że występowanie pewnego funkcjonalnego genu archeonów metanogennych nie odzwierciedla poziomu faktycznej produkcji metanu przez te mikroorganizmy, szczególnie w obecności antybiotyków. Tym samym, gen ten nie może być markerem aktywności tej grupy drobnoustrojów podczas fermentacji metanowej, pomimo że wielu badaczy dotychczas proponowało go do tej roli. To było dokonanie naukowe, które przedstawiłam we wniosku. Ale myślę, że to całokształt mojej działalności miał największe znaczenie. Mam ogromną przyjemność już wiele lat współpracować z dwiema badaczkami z mojej Katedry Inżynierii Ochrony Wód i Mikrobiologii Środowiskowej – prof. dr hab. inż. Moniką Harnisz i prof. dr hab. inż. Ewą Korzeniewską, które w mojej ocenie należą do pionierek w dziedzinie mikrobiologii środowiskowej. To one wprowadziły mnie w świat badań naukowych, jeszcze jako młodą studentkę. Przez kilka ostatnich lat, dzięki realizacji różnych projektów badawczych, moja praca przyjmowała charakter interdyscyplinarny, łącząc wiedzę i metody nie tylko z zakresu mikrobiologii, ale też inżynierii środowiska, chemii i biotechnologii. Jednak moje badania dotyczą przede wszystkim zjawiska antybiotykooporności w środowisku, ze szczególnym uwzględnieniem wpływu antropopresji na transmisje bakterii lekoopornych i genów lekooporności. W pracy naukowej kompleksowo analizowałam wpływ oczyszczalni ścieków, składowisk odpadów, a także obiektów takich jak biogazownie na szerzenie antybiotykooporności w środowisku.
Wróćmy na chwilę do wskazanego przez panią głównego dokonania naukowego. Zakładam, że skoro uzyskała pani inne wyniki niż niektórzy naukowcy, opublikowanie ich musiało wymagać odwagi, ale dało też chyba satysfakcję odkrycia czegoś nowego?
Tak, sporo satysfakcji. Mikroorganizmy metanogenne to grupa drobnoustrojów, które są bezpośrednio odpowiedzialne za syntezę metanu, odgrywającego istotną rolę w energetyce. Ważne jest, aby podczas fermentacji metanowej mieć możliwość skutecznej oceny aktywności metanogenów – czy nie obniża się ona, a jeśli tak, to pod wpływem czego. Od ich aktywności ściśle zależy efektywność produkcji metanu w bioreaktorach, czyli kluczowych elementach biogazowni. Konkretny gen został zaproponowany przez kilku naukowców jako marker tej aktywności, jednak wyniki moich badań jednoznacznie zaprzeczyły wiarygodności pomiarów na jego podstawie. To z kolei wskazuje na to, że obecnie brakuje skutecznego markera, który umożliwiłby przewidywanie destabilizacji fermentacji metanowej jeszcze w skali molekularnej. W swoich przyszłych działaniach naukowych na pewno uwzględnię tę kwestię. Wciąż jest wiele do odkrycia.
Kilka lat temu realizowała pani grant dla doktorantów w ramach konkursu Preludium, finansowanego przez Narodowe Centrum Nauki. Czy temat tamtych badań był powiązany z aktywnością mikroorganizmów metanogennych?
Nie. Ponieważ dotykam problemu antybiotykooporności w różnych środowiskach, w ramach realizacji własnego grantu na warsztat wzięłam odcieki, które powstają na składowiskach odpadów. Sprawdzałam, jak bardzo toksyczne są te odcieki, jakie bakterie lekooporne i geny lekooporności są w nich obecne, a także jaki wpływ na środowisko może wywierać ich zagospodarowywanie. Przede wszystkim myślę tu o środowisku wodnym, ponieważ odcieki składowiskowe często trafiają do oczyszczalni ścieków, gdzie włączane są w proces oczyszczania wraz ze ściekami komunalnymi. Ścieki oczyszczone są z kolei systematycznie odprowadzane do rzek.
Czym chciałaby się pani zająć teraz?
Cały czas działam w obszarze antybiotykooporności drobnoustrojów. Zawężam swoje cele i obecnie ukierunkowuję się na najbardziej newralgiczne obszary badawcze. Aktualnie zajmuję się analizą szerzenia wśród bakterii oporności na tzw. antybiotyki ostatniej szansy. To leki o najbardziej krytycznym znaczeniu klinicznym, czyli takie, którymi leczy się pacjentów, gdy wszystkie inne leki zawodzą. Antybiotyki te nazywa się też „lekami ostatniego rzutu”. Będę sprawdzała, jakie konkretnie mikroorganizmy izolowane ze środowiska wykazują oporność na te leki. Dodatkowo będę identyfikowała geny, które nadają na nie oporność. Szczególnie niebezpieczne jest zjawisko przekazywania takich genów pomiędzy bakteriami i powstawania nowych, niebezpiecznych szczepów, wobec których większość antybiotyków jest nieskuteczna. Co gorsze, oporność na leki może być przekazywana ze szczepów istotnych klinicznie, pochodzących od pacjentów, do szczepów, które występują w środowisku i na odwrót. Niesie to duże niebezpieczeństwo dla zdrowia publicznego. Coraz więcej leków jest nieskutecznych, bo poziom oporności drobnoustrojów na leki wzrasta. W tym kontekście istnieje ścisłe powiązanie między środowiskiem naturalnym, a środowiskiem klinicznym.
Czy to wyróżnienie i stypendium z programu START motywuje do dalszej pracy?
Na pewno tak! Jest to wyróżnienie, z którego mogę być dumna i potwierdzenie, że badania, które realizuję, zostały zauważone i uznane za istotne. Oprócz samego uznania, ważne jest też wsparcie finansowe w formie rocznego stypendium, łącznie w wysokości 30 tys. złotych, podzielonych na 12 rat. Możliwość finansowego podreperowania budżetu przez ten rok umożliwia pełne poświęcenie się pracy badawczej, co jest szczególnie ważne dla młodych osób, chcących kontynuować karierę naukową w Polsce.
Rozmawiała Anna Wysocka
fot. Janusz Pająk
Dr inż. Małgorzata Czatzkowska pracuje w Katedrze Inżynierii Ochrony Wód i Mikrobiologii Środowiskowej. Zajmuje się badaniem problematyki antybiotykooporności w środowisku. Jest autorką kilkunastu publikacji naukowych opublikowanych w czasopismach z listy JC i realizatorką wielu projektów badawczych.